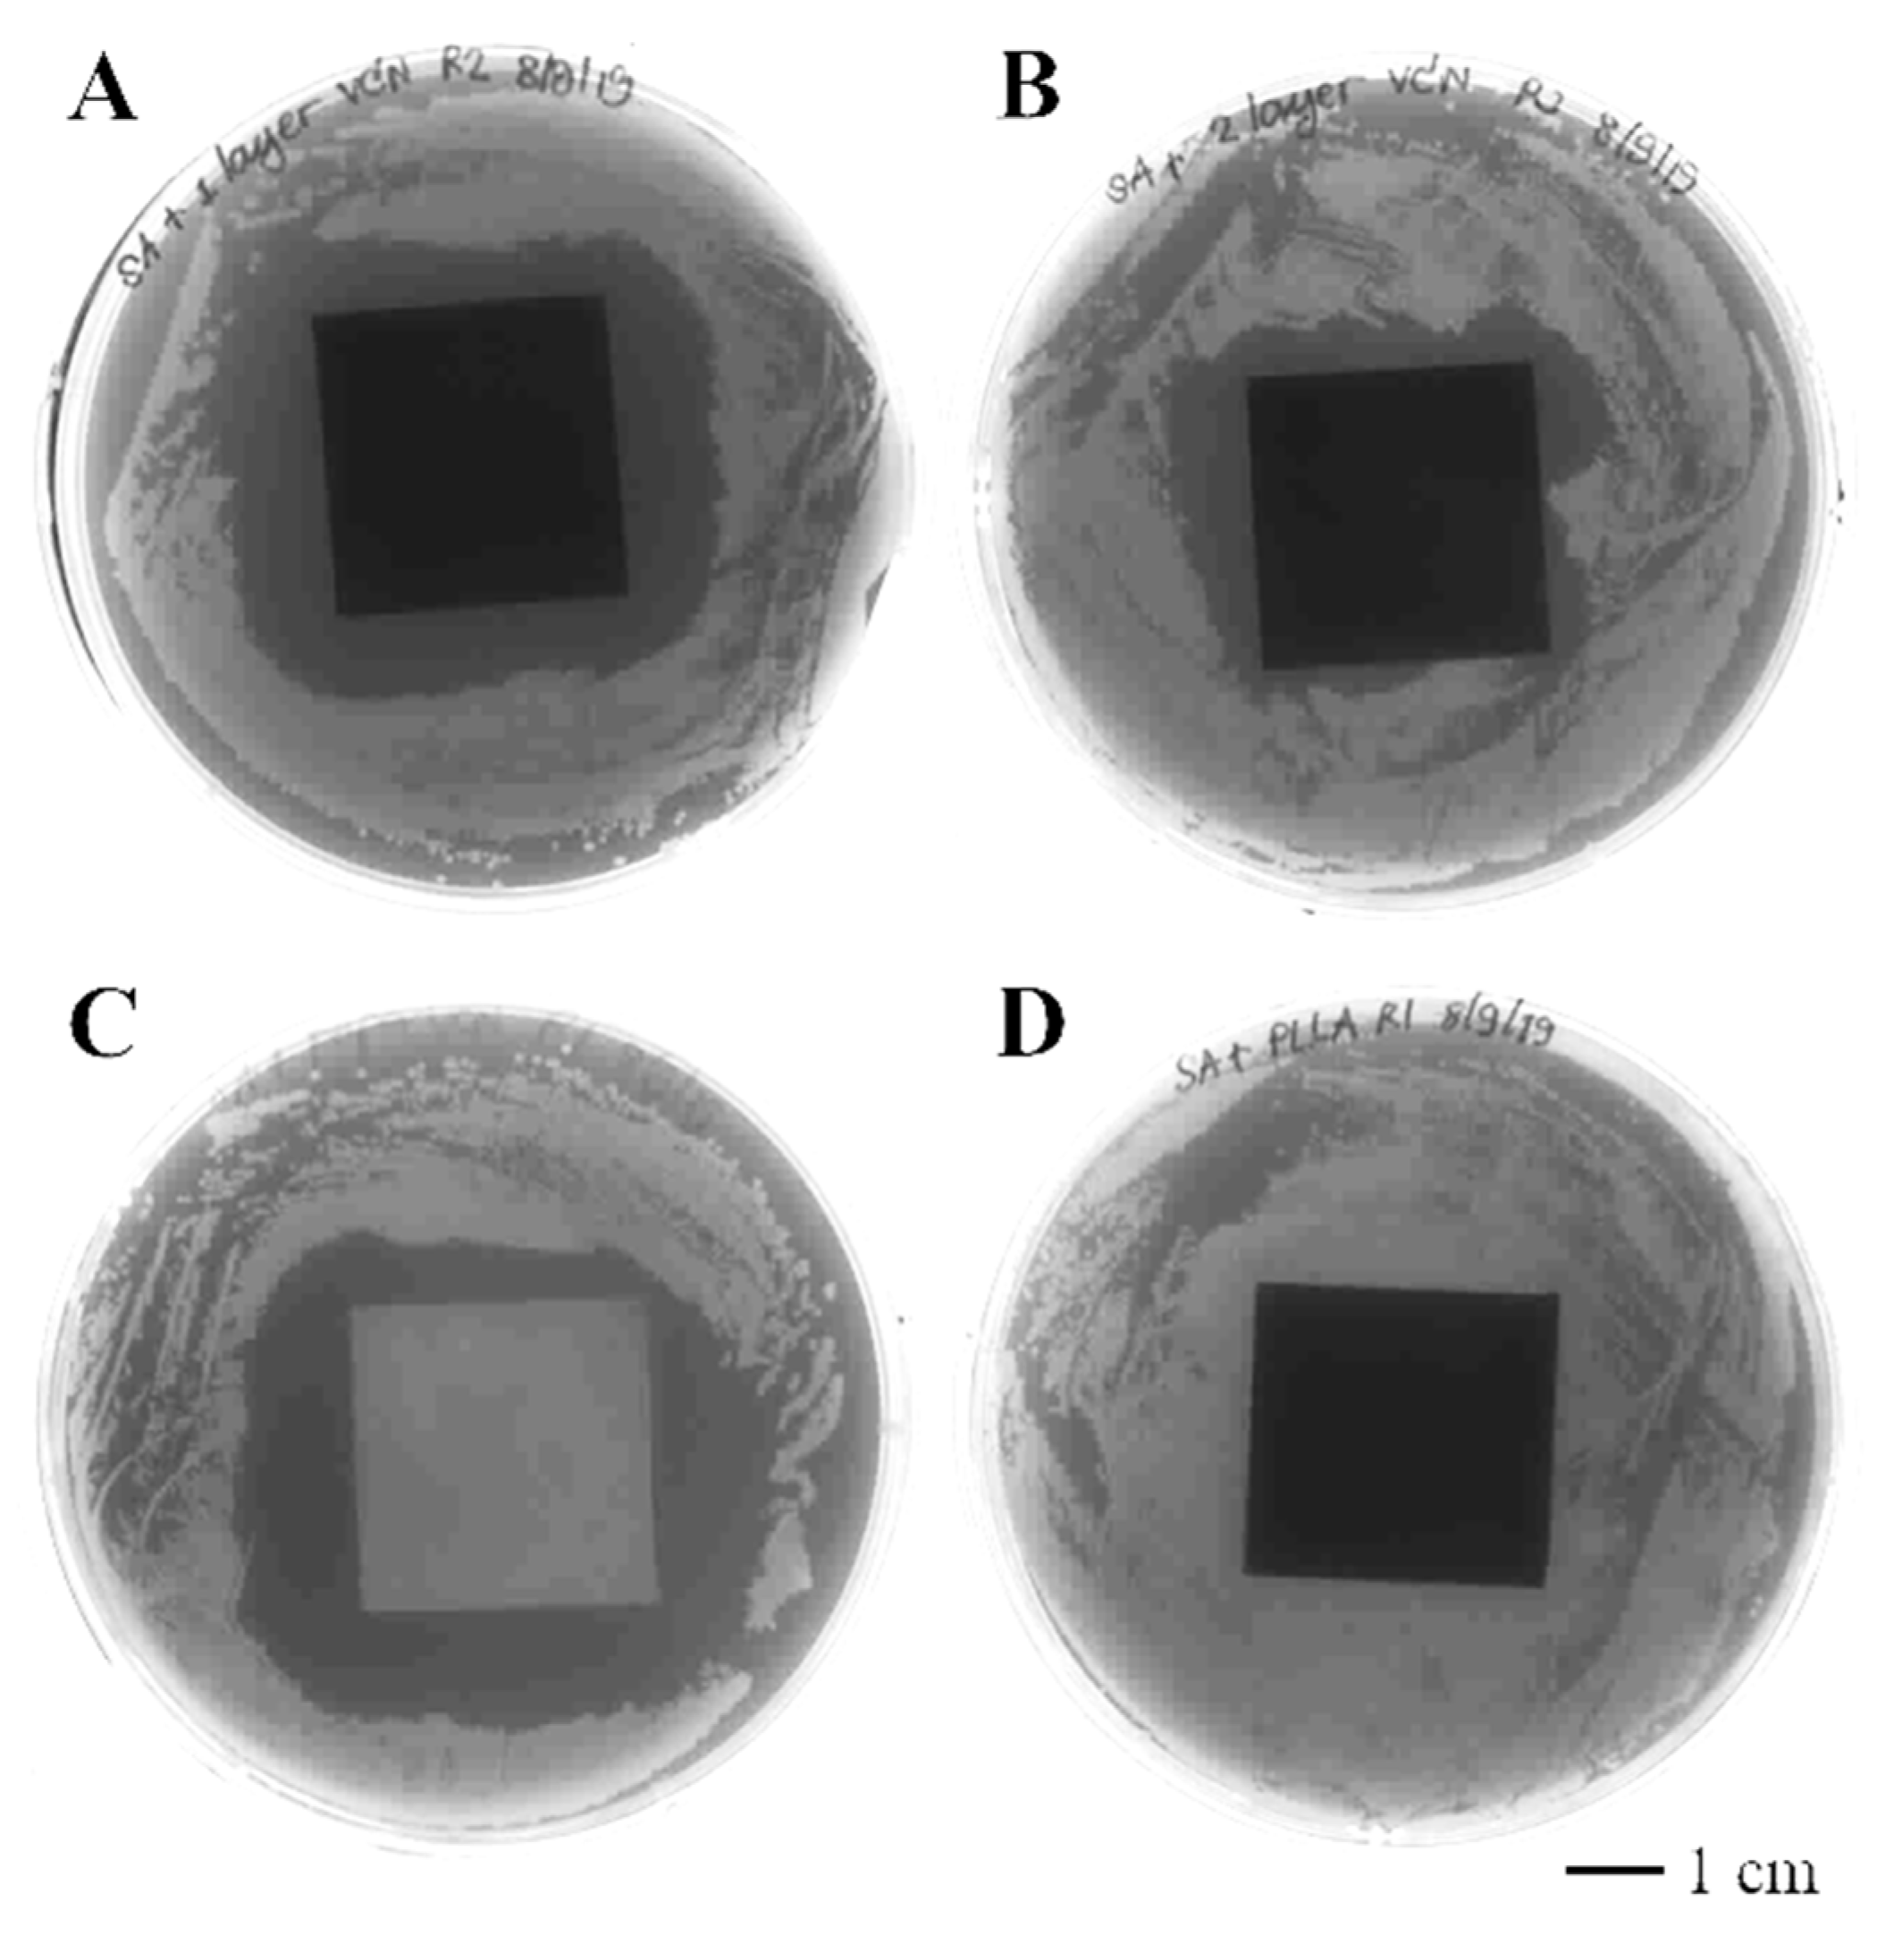
Polymers 14 03493 g006 550

Controlled Release Mechanism of Vancomycin from Double-Layer Poly-L-Lactic Acid-Coated Implants for Prevention of Bacterial Infection
Abstract
:1. Introduction
2. Materials and Methods
2.1. Coating of Vancomycin-PLLA on Stainless Steel Plates
2.2. Characterization of the Vancomycin-Loaded PLLA Coating
2.2.1. Morphology and Thickness
2.2.2. Adhesive Strength between the Vancomycin-PLLA Layer and Stainless Steel Substrate
2.3. In Vitro Release of Vancomycin
2.4. Antibacterial Activity
2.5. Cytotoxicity Study
2.6. Statistical Analysis
3. Results and Discussion
3.1. Characterization of the Vancomycin-Loaded PLLA Coating
3.2. Release Profile and Release Mechanism of Vancomycin from the PLLA Coating
3.3. Antibacterial Activity of Vancomycin-Loaded PLLA
3.4. Cytotoxicity of the Vancomycin-PLLA Delivery System
4. Conclusions
Supplementary Materials
Author Contributions
Funding
Institutional Review Board Statement
Informed Consent Statement
Data Availability Statement
Conflicts of Interest
References
- Jennsen, L.K.; Koch, J.; Aalbaek, B.; Moodley, A.; Bjarnsholt, T.; Kragh, K.N.; Petersen, A.; Jensen, H.E. Early implant-associated osteomyelitis in a peri-implanted bacterial reservoir. APMIS 2017, 125, 38–45. [Google Scholar] [CrossRef]
- Darouiche, R.O. Treatment of infections associated with surgical implants. N. Engl. J. Med. 2004, 350, 1422–1429. [Google Scholar] [CrossRef] [PubMed]
- Gimza, B.D.; Cassat, J.E. Mechanism of antibiotic failure during Straphylococcus aureus osteomyelitis. Front. Immunol. 2021, 12, 638085. [Google Scholar] [CrossRef] [PubMed]
- Jaeblon, T. Polymethylmethacrylate: Properties and contemporary uses in orthopaedics. J. Am. Acad. Orthop. Surg. 2010, 18, 297–305. [Google Scholar] [CrossRef] [PubMed]
- Arora, M.; Chan, E.K.; Gupta, S.; Diwan, A.D. Polymethylmethacrylate bone cements and additives: A review of the literature. World J. Orthop. 2013, 4, 67–74. [Google Scholar] [CrossRef]
- Gálvez-López, R.; Peña-Monje, A.; Antelo-Lorenzo, R.; Guardia-Olmedo, J.; Moliz, J.; Hernández-Quero, J.; Parra-Ruiz, J. Elution kinetics, antimicrobial activity, and mechanical properties of 11 different antibiotic loaded acrylic bone cement. Diagn. Microbiol. Infect. Dis. 2014, 78, 70–74. [Google Scholar] [CrossRef]
- Duewelhenke, N.; Krut, O.; Eysel, P. Influence on Mitochondria and Cytotoxicity of Different Antibiotics Administered in High Concentrations on Primary Human Osteoblasts and Cell Lines. Antimicrob. Agents Chemother. 2007, 51, 54–63. [Google Scholar] [CrossRef]
- Rottman, M.; Goldberg, J.; Hacking, S.A. Titanium-Tethered Vancomycin Prevents Resistance to Rifampicin in Staphylococcus aureus in vitro. PLoS ONE 2012, 7, e52883. [Google Scholar] [CrossRef]
- Zhang, B.G.X.; Myers, D.E.; Wallace, G.G.; Brandt, M.; Choong, P.F.M. Bioactive Coatings for Orthopaedic Implants—Recent Trends in Development of Implant Coatings. Int. J. Mol. Sci. 2014, 15, 11878–11921. [Google Scholar] [CrossRef]
- Antoci, V.J.; Adams, C.S.; Hickok, N.J.; Shapiro, I.M.; Parvizi, J. Antibiotics for Local Delivery Systems Cause Skeletal Cell Toxicity In Vitro. Clin. Orthop. Relat. Res. 2007, 462, 200–206. [Google Scholar] [CrossRef]
- Shahid, A.; Aslam, B.; Muzammil, S.; Aslam, N.; Shahid, M.; Almatroudi, A.; Allemailem, K.S.; Saqalein, M.; Nisar, M.A.; Rasool, M.H.; et al. The prospects of antimicrobial coated medical implants. J. Appl. Biomater. Funct. Mater. 2021, 19, 22808000211040304. [Google Scholar] [CrossRef] [PubMed]
- Qiu, H.; Si, Z.; Lou, Y.; Feng, P.; Wu, X.; Hou, W.; Zhu, Y.; Chan-Park, M.B.; Xu, L.; Huang, D. The mechanisms and the applications of antibacterial polymers in surface modification on medical devices. Front. Bioeng. Biotechnol. 2020, 8, 910. [Google Scholar] [CrossRef] [PubMed]
- DeStefano, V.; Khan, S.; Tabada, A. Applications of PLA in modern medicine. Eng. Regen. 2020, 1, 76–87. [Google Scholar] [CrossRef]
- Ribeiro, D.; Sencadas, V.; Costa, C.M.; Ribelles, J.L.G.; Lanceros-Mendez, S. Tailoring the morphology and crystallinity of poly(L-lactide acide) electrospun membranes. Sci. Technol. Adv. Mater. 2011, 12, 015001. [Google Scholar] [CrossRef] [PubMed]
- Farah, S.; Anderson, D.G.; Langer, R. Physical and mechanical properties of PLA, and their functions in widespread applications—A comprehensive review. Adv. Drug Deliv. Rev. 2016, 107, 367–392. [Google Scholar] [CrossRef]
- Pohanka, M. D-lactic acid as a metabolite: Toxicity, diagnosis, and detection. BioMed Res. Int. 2020, 2020, 3419034. [Google Scholar] [CrossRef]
- He, C.; Chen, Q.; Yarmolenko, M.A.; Rogachev, A.A.; Piliptsou, D.G.; Jiang, X.; Rogachev, A.V. Structure and antibacterial activity of PLA-based biodegradable nanocomposite coatings by electron beam deposition from active gas phase. Prog. Org. Coat. 2018, 123, 282–291. [Google Scholar] [CrossRef]
- Dwivedi, A.; Mazumder, A.; Nasongkla, N. Layer-by-layer nanocating of antibacterial noisome on orthopedic implants. Int. J. Pharm. 2018, 547, 235–243. [Google Scholar] [CrossRef]
- Harting, R.; Johnston, K.; Petersen, S. Correlating in vitro degradation and drug release kinetics of biopolymer-based drug delivery systems. Int. J. Biobased Plast. 2019, 1, 8–21. [Google Scholar] [CrossRef]
- Lei, W.-S.; Mittal, K.; Yu, Z. Adhesion measurement of coatings on biodevices/implants: A critical review. Rev. Adhes. Adhes. 2016, 4, 367–397. [Google Scholar] [CrossRef]
- Cevher, E.; Orhan, Z.; Mulazimmouglu, L.; Sensoy, D.; Alper, M.; Yildiz, A.; Ozsoy, Y. Characterization of biodegradable chitosan microspheres containing vancomycin and treatment of experimental osteomyelitis caused by methicillin-resistant Staphylococcus aureus with prepared microspheres. Int. J. Pharm. 2006, 317, 127–135. [Google Scholar] [CrossRef] [PubMed]
- Arizmendi-Morquecho, A.; Chavez-Valdez, A.; Navarro, C.H.; Moreo, K.J. Performance evaluation of chitosan/hydroxyapatite composite coating on ultrahigh molecular weight polyethylene. Polym. Test. 2013, 32, 32–37. [Google Scholar] [CrossRef]
- Fooks, J.R.; McGilveray, I.J.; Strickland, R.D. Colorimetric assay and improved method for identification of vancomycin hydrochloride. J. Pharm. Sci. 1968, 57, 314–317. [Google Scholar] [CrossRef] [PubMed]
- Ordikhani, F.; Tamjid, E.; Simchi, A. Characterization and antibacterial performance of electrodeposited chitosan–vancomycin composite coatings for prevention of implant-associated infections. Mater. Sci. Eng. C 2014, 41, 240–248. [Google Scholar] [CrossRef]
- Graziano, M.U.; Graziano, K.U.; Pinto, F.M.G.; Bruna, C.Q.M.; Souza, R.Q.; Lascala, C.A. Effectiveness of disinfection with alcohol 70% (w/v) of contaminated surfaces not previously cleaned. Rev. Latino-Am. Enferm. 2013, 21, 618–623. [Google Scholar] [CrossRef]
- Biological Evaluation of Medical Devices—Part 5: Tests for in Vitro Cytotoxicity (ISO Standard No. 10993-5:2009). Available online: https://www.iso.org/standard/36406.html (accessed on 6 July 2022).
- Grosso, D. How to exploit the full potential of the dip-coating process to better control film formation. J. Mater. Chem. 2011, 21, 17033–17038. [Google Scholar] [CrossRef]
- Figueira, R.B.; Silva, C.J.R.; Pereira, E.V. Influence of experimental parameters using the dip-coating method on the barrier performance of hybrid sol-gel coatings in strong alkaline environments. Coatings 2015, 5, 124–141. [Google Scholar] [CrossRef]
- Escalé, P.; Rubatat, L.; Billon, L.; Save, M. Recent advances in honeycomb-structured porous polymer films prepared via breath figures. Eur. Polym. J. 2012, 48, 1001–1025. [Google Scholar] [CrossRef]
- Heng, L.; Wang, B.; Li, M.; Zhang, Y.; Jiang, L. Advances in Fabrication Materials of Honeycomb Structure Films by the Breath-Figure Metho. Materials 2013, 6, 460–482. [Google Scholar] [CrossRef]
- Loiola, L.M.D.; Más, B.A.; Duek, E.A.R.; Felisberti, M.I. Amphiphilic multiblock copolymers of PLLA, PEO and PPO blocks: Synthesis, properties and cell affinity. Eur. Polym. J. 2015, 68, 618–629. [Google Scholar] [CrossRef]
- Ali, T.; Shoaib, M.H.; Yousuf, R.I.; Jabeen, S.; Muhammad, I.N.; Tariq, A. Use of hydrophilic and hydrophobic polymers for the development of controlled release tizanidine matrix tablets. Braz. J. Pharm. Sci. 2014, 50, 799–818. [Google Scholar] [CrossRef]
- Zhang, L.; Yan, J.; Yin, Z.; Tang, C.; Guo, Y.; Li, D.; Wei, B.; Xu, Y.; Gu, Q.; Wang, L. Electrospun vancomycin-loaded coating on titanium implants for the prevention of implant-associated infections. Int. J. Nanomed. 2014, 9, 3027–3036. [Google Scholar] [CrossRef]
- Boot, W.; Gawlitta, D.; Nikkels, P.G.J.; Pouran, B.; van Rijen, M.H.P.; Dhert, W.J.A.; Vogely, H.C. Hyaluronic acid-based hydrogel coating does not affect bone apposition at the implant surface in a rabbit model. Clin. Orthop. Relat. Res. 2017, 475, 1911–1919. [Google Scholar] [CrossRef] [PubMed]
- Mohseni, E.; Zalnezhad, E.; Bushroa, A.R. Comparative investigation on the adhesion of hydroxyapatite coating on Ti-6Al-4 V implant: A review paper. Int. J. Adhes. Adhes. 2014, 48, 238–257. [Google Scholar] [CrossRef]
- Dashevskiy, I.; Balueva, A.; Todebush, P.; Campbell, C.; Magana, J.; Clement, N. On Estimation of Adhesive Strength of Implants Bioactive Coating with Titanium by Density Functional Theory and Molecular Dynamics Simulations. Mater. Res. 2019, 22, e20190030. [Google Scholar] [CrossRef]
- Yamada, S.; Maeda, H.; Obata, A.; Lohbauer, U.; Yamamoto, A.; Kasuga, T. Cytocompatibility of Siloxane-Containing Vaterite/Poly(l-lactic acid) Composite Coatings on Metallic Magnesium. Materials 2013, 6, 5857–5869. [Google Scholar] [CrossRef]
- Kannan, M.B. Biodegradable polymeric coatings for surface modification of magnesium-based biomaterials. In Surface Modification of Magnesium and Its Alloys for Biomedical Applications; Narayanan, T.S.N.S., Park, I.-S., Lee, M.-H., Eds.; Woodhead Publishing: Sawston, UK, 2015; pp. 355–376. [Google Scholar]
- Morris, B.A. Influence of Stress on Peel Strength of Acid Copolymers to Foil. J. Reinf. Plast. Compos. 2002, 21, 1243–1255. [Google Scholar] [CrossRef]
- Fu, Y.; Kao, W.J. Drug release kinetics and transport mechanisms of non-degradable and degradable polymeric delivery systems. Expert Opin. Drug Deliv. 2010, 7, 429–444. [Google Scholar] [CrossRef]
- ISO 10477:2020; Dentistry-Polymer-Based Crown and Bridge Materials. International Organization for Standardization: Geneva, Switzerland, 2020. Available online: https://www.iso.org/obp/ui/#iso:std:iso:10477:ed-4:v1:en (accessed on 6 July 2022).
- Hatzenbuehler, J.; Pulling, T.J. Diagnosis and management of osteomyelitis. Am. Fam. Physician 2011, 84, 1027–1033. [Google Scholar]
- Fang, C.; Wong, T.M.; To, K.K.; Wong, S.S.; Lau, T.W.; Leung, F. Infection after fracture osteosynthesis—Part II. J. Orthop. Surg. (Hong Kong) 2017, 25, 2309499017692714. [Google Scholar] [CrossRef]
- Dash, S.; Murthy, N.P.; Nath, L.; Chwdhury, P. Kinetic modeling on drug release from kinetic controlled drug delivery systems. Acta Pol. Pharm. 2010, 67, 217–223. [Google Scholar]
- Prakash, V.; Lewis, J.S.; Jorgensen, J.H. Vancomycin MICs for Methicillin-Resistant Staphylococcus aureus Isolates Differ Based upon the Susceptibility Test Method Used. Antimicrob. Agents Chemother. 2008, 52, 4528. [Google Scholar] [CrossRef] [PubMed] [Green Version]
- Huang, X.; Brazel, C.S. On the importance and mechanisms of burst release in matrix-controlled drug delivery systems. J. Control. Release 2001, 73, 121–136. [Google Scholar] [CrossRef]
- Venkatraman, S.; Boey, F. Release profiles in drug-eluting stents: Issues and uncertainties. J. Control. Release 2007, 120, 149–160. [Google Scholar] [CrossRef]
- Thote, A.J.; Chappell, J.T.; Kumar, R.; Gupta, R.B. Reduction in the Initial-Burst Release by Surface Crosslinking of PLGA Microparticles Containing Hydrophilic or Hydrophobic Drugs. Drug Dev. Ind. Pharm. 2005, 31, 43–57. [Google Scholar] [CrossRef] [PubMed]
- Kumbar, S.G.; Kulkarni, A.R.; Aminabhavi, T.M. Crosslinked chitosan microspheres for encapsulation of diclofenac sodium: Effect of crosslinking agent. J. Microencapsul. 2002, 19, 173–180. [Google Scholar] [CrossRef] [PubMed]
- Traub, W.H.; Leonhard, B. Heat stability of the antimicrobial activity of sixty-two antibacterial agents. J. Antimicrob. Chemother. 1995, 35, 149–154. [Google Scholar] [CrossRef]
- Zafalon, A.; Juvino, V.; Santos, D.; Lugão, A.B.; Rangari, V.; Temesgen, S.; Parra, D.F. Stability of the Neomycin Antibiotic in Irradiated Polymeric Biomaterials. Eur. J. Biomed. Pharm. Sci. 2018, 5, 49–57. [Google Scholar]
- Livingston, M.; Tan, A. Coating Techniques and Release Kinetics of Drug-Eluting Stents. J. Med. Devices 2019, 10, 010801. [Google Scholar] [CrossRef]
- Raval, A.; Parikh, J.; Engineer, C. Mechanism of controlled release kinetics from medical devices. Braz. J. Chem. Eng. 2010, 27, 211–225. [Google Scholar] [CrossRef]
- Domenek, S.; Fernandes-Nassar, S.; Ducruet, V. Rheology, Mechanical Properties, and Barrier Properties of Poly(lactic acid). In Synthesis, Structure and Properties of Poly (Lactic Acid); Maria, D.L., Androsch, R., Eds.; Springer International Publishing: Cham, Switzerland, 2018; pp. 303–341. [Google Scholar]
- Proikakis, C.; Mamouzelos, N.; Tarantili, P.; Andreopoulos, A. Swelling and hydrolytic degradation of poly(d, l-lactic acid) in aqueous solutions. Polym. Degrad. Stab. 2006, 91, 614–619. [Google Scholar] [CrossRef]
- Ismat, A.; Walter, N.; Baertl, S.; Mika, J.; Lang, S.; Kerschbaum, M.; Alt, V.; Rupp, M. Antibiotic cement coating in orthopedic surgery: A systematic review of reported clinical techniques. J. Orthop. Traumatol. 2021, 22, 56. [Google Scholar] [CrossRef]

| Formulation | Average Thickness (μm) | Coefficient of Variance (%) |
|---|---|---|
| PLLA coating | 44.57 ± 2.51 | 5.63 |
| Vancomycin-PLLA coating | 44.43 ± 10.13 | 22.79 |
| Vancomycin-PLLA coating with a drug-free topcoat | 54.09 ± 3.46 | 6.39 |
| Sample | Bonding Strength (MPa) |
|---|---|
| PLLA coating and stainless steel | 1.80 ± 0.49 |
| Vancomycin-PLLA coating and stainless steel | 1.87 ± 0.45 |
| Vancomycin-PLLA coating with a topcoat and stainless steel | >5 MPa |
| Model | Equation | Vancomycin-PLLA Coating | Vancomycin-PLLA Coating with a Drug-Free Topcoat | ||||
|---|---|---|---|---|---|---|---|
| K | n | R2 | k | n | R2 | ||
| Zero order | 0.0702 | - | 0.7284 | 0.0032 | - | 0.3945 | |
| First- order | 0.2253 | - | 0.9191 | 0.0096 | - | 0.9744 | |
| Higuchi | 0.2882 | - | 0.9401 | 0.0557 | - | 0.9689 | |
| Korsmeyer–Peppas | 0.315 | 0.206 | 0.9907 | 0.049 | 0.54 | 0.9995 | |
| % Reduction in S. aureus Population | Inhibition Area (cm2) | |
|---|---|---|
| PLLA-vancomycin without drug-free topcoat | 91.77 ± 0.42 | 19.71 ± 2.25 |
| PLLA-vancomycin with drug-free topcoat | 81.77 ± 9.57 | 12.97 ± 1.3 |
| Positive control | 100.00 ± 0.00 | 24.56 ± 4.96 |
| Negative control | Increase in the number of CFU | No inhibition zone |
Publisher’s Note: MDPI stays neutral with regard to jurisdictional claims in published maps and institutional affiliations. |
© 2022 by the authors. Licensee MDPI, Basel, Switzerland. This article is an open access article distributed under the terms and conditions of the Creative Commons Attribution (CC BY) license (https://creativecommons.org/licenses/by/4.0/).
Share and Cite
Thamvasupong, P.; Viravaidya-Pasuwat, K. Controlled Release Mechanism of Vancomycin from Double-Layer Poly-L-Lactic Acid-Coated Implants for Prevention of Bacterial Infection. Polymers 2022, 14, 3493. https://doi.org/10.3390/polym14173493
Thamvasupong P, Viravaidya-Pasuwat K. Controlled Release Mechanism of Vancomycin from Double-Layer Poly-L-Lactic Acid-Coated Implants for Prevention of Bacterial Infection. Polymers. 2022; 14(17):3493. https://doi.org/10.3390/polym14173493
Chicago/Turabian StyleThamvasupong, Papon, and Kwanchanok Viravaidya-Pasuwat. 2022. "Controlled Release Mechanism of Vancomycin from Double-Layer Poly-L-Lactic Acid-Coated Implants for Prevention of Bacterial Infection" Polymers 14, no. 17: 3493. https://doi.org/10.3390/polym14173493
APA StyleThamvasupong, P., & Viravaidya-Pasuwat, K. (2022). Controlled Release Mechanism of Vancomycin from Double-Layer Poly-L-Lactic Acid-Coated Implants for Prevention of Bacterial Infection. Polymers, 14(17), 3493. https://doi.org/10.3390/polym14173493

